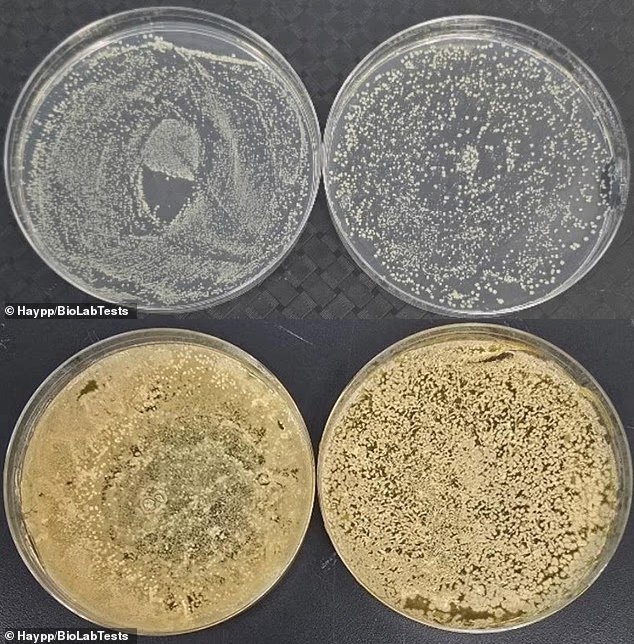
개봉 후 2주 후에 세균을 채취해 배양한 결과. 위쪽부터 순서대로 흡입구, 기기 표면이다. 양측에서 모두 세균이 빽빽하게 들어차 있다. Haypp/BioLabTests 제공

전자담배 흡입구 ‘세균 득실’…공중화장실 변기의 3000배
- 동아닷컴
-
입력 2025년 11월 23일 13시 00분
공유하기
글자크기 설정

전자담배 흡입구의 세균 오염도가 공중화장실 변기보다 최대 3000배 높다는 연구 결과가 공개되며, ‘덜 해롭다’는 인식과 달리 기기 위생 실태가 심각한 수준이라는 지적이 나왔다. 연구진은 전자담배를 사용하는 경우 “최소 3일에 한 번은 세척해야 한다”고 경고했다.
19일(현지 시각) 영국 데일리메일에 따르면, 영국 코번트리의 독립 연구소 바이오랩테스트(BioLabTests)는 온라인 니코틴 유통업체 헤이프(Haypp)와 함께 일회용 전자담배를 2주간 사용하며 오염도를 추적했다. 연구팀은 널리 사용되는 딸기맛 일회용 전자담배 흡입구를 개봉 직후부터 24·48·72시간·1주·2주 간격으로 채취해 배양했다.
● 변기보다 최대 3000배…전자담배 흡입구, 왜 이렇게 더러운가
전자담배에서 확인된 미생물은 바닥 먼지와 공기에 흔한 바실루스, 피부에 상재하는 포도상구균, 장내 세균인 엔테로코커스, 호흡기 자극을 유발할 수 있는 효모·곰팡이 등이다. 대변 오염 지표로 알려진 대장균까지도 검출됐다.
가장 더러운 부위는 역시 입이 직접 닿는 흡입구였다. 따뜻하고 습한 환경에 사용자의 침과 입안 세균이 더해지면서 세균과 곰팡이가 폭발적으로 증식했다. 연구진은 “인간의 입에는 약 700종의 박테리아가 사는 것으로 알려져 있다. 입이 닿는 부분이 더러운 것은 어찌 보면 당연한 결과”라고 설명했다.
● “전자담배는 만질 때마다 오염된다”…전문가들이 제시한 관리 기준

심지어 기기 표면에 끈적이는 미생물층인 ‘바이오필름(Biofilm)’이 형성됐을 가능성도 제기했다. 바이오필름은 미생물이 엉겨 붙어 구축한 강력한 막으로, 일반적인 세척만으로는 제거가 쉽지 않다. 똑같이 변기만큼 더럽다고 지적받는 스마트폰에서도 종종 발견되는 현상이다.
연구를 이끈 미생물학자 레이놀드 음포푸는 “전자담배는 ‘한 번 만질 때마다, 한 번 빨 때마다’ 오염이 쌓이는 물건”이라며 “정기적인 세척과 예외적으로 철저한 위생 관리가 필수적이다”라고 강조했다.
실험에 참여한 헤이프 측은 전자담배 청소 주기를 ‘최소 3일에 한 번’으로 제시했다. 헤이프 관계자는 “일주일에 한 번 세척해도 된다는 말도 있지만, 그건 너무 길다”며 “알코올 솜이나 세정제를 묻힌 천으로 흡입구와 몸통을 닦고, 제품을 분리해 세척해야 한다”고 권고했다.
국내에서도 전자담배는 이미 대중화했다. 특히 지난해 기준 전자담배 판매량이 35억3000만 갑에 달하는 등 사용 인구가 빠르게 증가하고 있다. 전자담배 제조사들은 일반 담배보다 독성 화학 물질이 적다며 ‘덜 해로운 선택지’로 홍보해 왔지만, 심부전·폐 질환·잇몸 질환과의 연관성을 지적하는 연구가 이어졌다.
여기에 기기 오염 문제가 새롭게 제기되면서 전문가들은 “전자담배는 무엇을 피우느냐보다 어떻게 관리하느냐가 건강을 좌우한다”고 조언했다.
© dongA.com All rights reserved. 무단 전재, 재배포 및 AI학습 이용 금지
트렌드뉴스
-
1
“승우야 하늘나라서 잘 지내지?” 순직 아들에 눈물의 편지
-
2
美국방 “유럽-아시아, 호르무즈 무임승차 끝났다”
-
3
‘AI변압기’ 효성重 1년새 주가 8배로… 메타는 “내달 8000명 해고”
-
4
세금 걱정은 덜고 월 배당은 따박따박[은퇴 레시피]
-
5
“노화 시력 되돌린다”…오메가3 아닌 ‘이 지방산’ 주목 [노화설계]
-
6
모스크바 공항에 나타난 북한 청년들[주성하의 ‘北토크’]
-
7
“길이 19m 거대 문어 존재 가능성”…백악기 바다 최상위 포식자였나
-
8
트럼프 ‘골드카드’ 굴욕…14억짜리 美영주권, 딱 1건 발급
-
9
한동훈 부산북갑 출마 “좋지 않게 본다” 49%
-
10
“檢이라며 휴대전화 연락”… “그 번호 쓰는 직원 없어요”
-
1
장동혁, 사퇴 요구 일축…“선거 마무리하고 평가받겠다”
-
2
장동혁 “사퇴가 선거 도움 되겠나…지지율 낮은건 내부갈등 탓”
-
3
한동훈 부산북갑 출마 “좋지 않게 본다” 49%
-
4
李 “터무니없어”…정동영 “저의 의심”…위성락 “사달났다”
-
5
李, 장특공제 또 겨냥 “살지도 않는 1주택 감세는 투기권장정책”
-
6
李, 하노이서 쌀국수 식사…“베트남은 어느 식당 들어가도 실패 안해”
-
7
내란특검, ‘평양무인기 의혹’ 윤석열 1심 징역 30년 구형
-
8
靑 “정동영 북핵 발언, 원래 韓美간 비밀인데 다른 데서 듣고 말해”
-
9
美국방 “유럽-아시아, 호르무즈 무임승차 끝났다”
-
10
유승준, 태진아 LA 콘서트 깜짝 등장…교포 관객들에 눈물 속 인사
트렌드뉴스
-
1
“승우야 하늘나라서 잘 지내지?” 순직 아들에 눈물의 편지
-
2
美국방 “유럽-아시아, 호르무즈 무임승차 끝났다”
-
3
‘AI변압기’ 효성重 1년새 주가 8배로… 메타는 “내달 8000명 해고”
-
4
세금 걱정은 덜고 월 배당은 따박따박[은퇴 레시피]
-
5
“노화 시력 되돌린다”…오메가3 아닌 ‘이 지방산’ 주목 [노화설계]
-
6
모스크바 공항에 나타난 북한 청년들[주성하의 ‘北토크’]
-
7
“길이 19m 거대 문어 존재 가능성”…백악기 바다 최상위 포식자였나
-
8
트럼프 ‘골드카드’ 굴욕…14억짜리 美영주권, 딱 1건 발급
-
9
한동훈 부산북갑 출마 “좋지 않게 본다” 49%
-
10
“檢이라며 휴대전화 연락”… “그 번호 쓰는 직원 없어요”
-
1
장동혁, 사퇴 요구 일축…“선거 마무리하고 평가받겠다”
-
2
장동혁 “사퇴가 선거 도움 되겠나…지지율 낮은건 내부갈등 탓”
-
3
한동훈 부산북갑 출마 “좋지 않게 본다” 49%
-
4
李 “터무니없어”…정동영 “저의 의심”…위성락 “사달났다”
-
5
李, 장특공제 또 겨냥 “살지도 않는 1주택 감세는 투기권장정책”
-
6
李, 하노이서 쌀국수 식사…“베트남은 어느 식당 들어가도 실패 안해”
-
7
내란특검, ‘평양무인기 의혹’ 윤석열 1심 징역 30년 구형
-
8
靑 “정동영 북핵 발언, 원래 韓美간 비밀인데 다른 데서 듣고 말해”
-
9
美국방 “유럽-아시아, 호르무즈 무임승차 끝났다”
-
10
유승준, 태진아 LA 콘서트 깜짝 등장…교포 관객들에 눈물 속 인사
-
- 좋아요
- 0개
-
- 슬퍼요
- 0개
-
- 화나요
- 0개

![구두 대신 운동화 신는 승무원 [횡설수설/우경임]](https://dimg.donga.com/a/464/260/95/1/wps/NEWS/FEED/Donga_Home_News2/133809736.2.thumb.jpg)

댓글 0